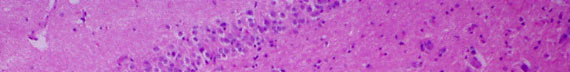

Introduction

The almost pure lymphocytic perivascular
cuffs are consistent with chronic encephalitis
(= inflammation of the brain), most likely due to a viral infection.
|
||
 |
 |
|
 |
||
Elsewhere in the hippocampus, there is multifocal gliosis in addition to perivascular cuffing by inflammatory cells.
